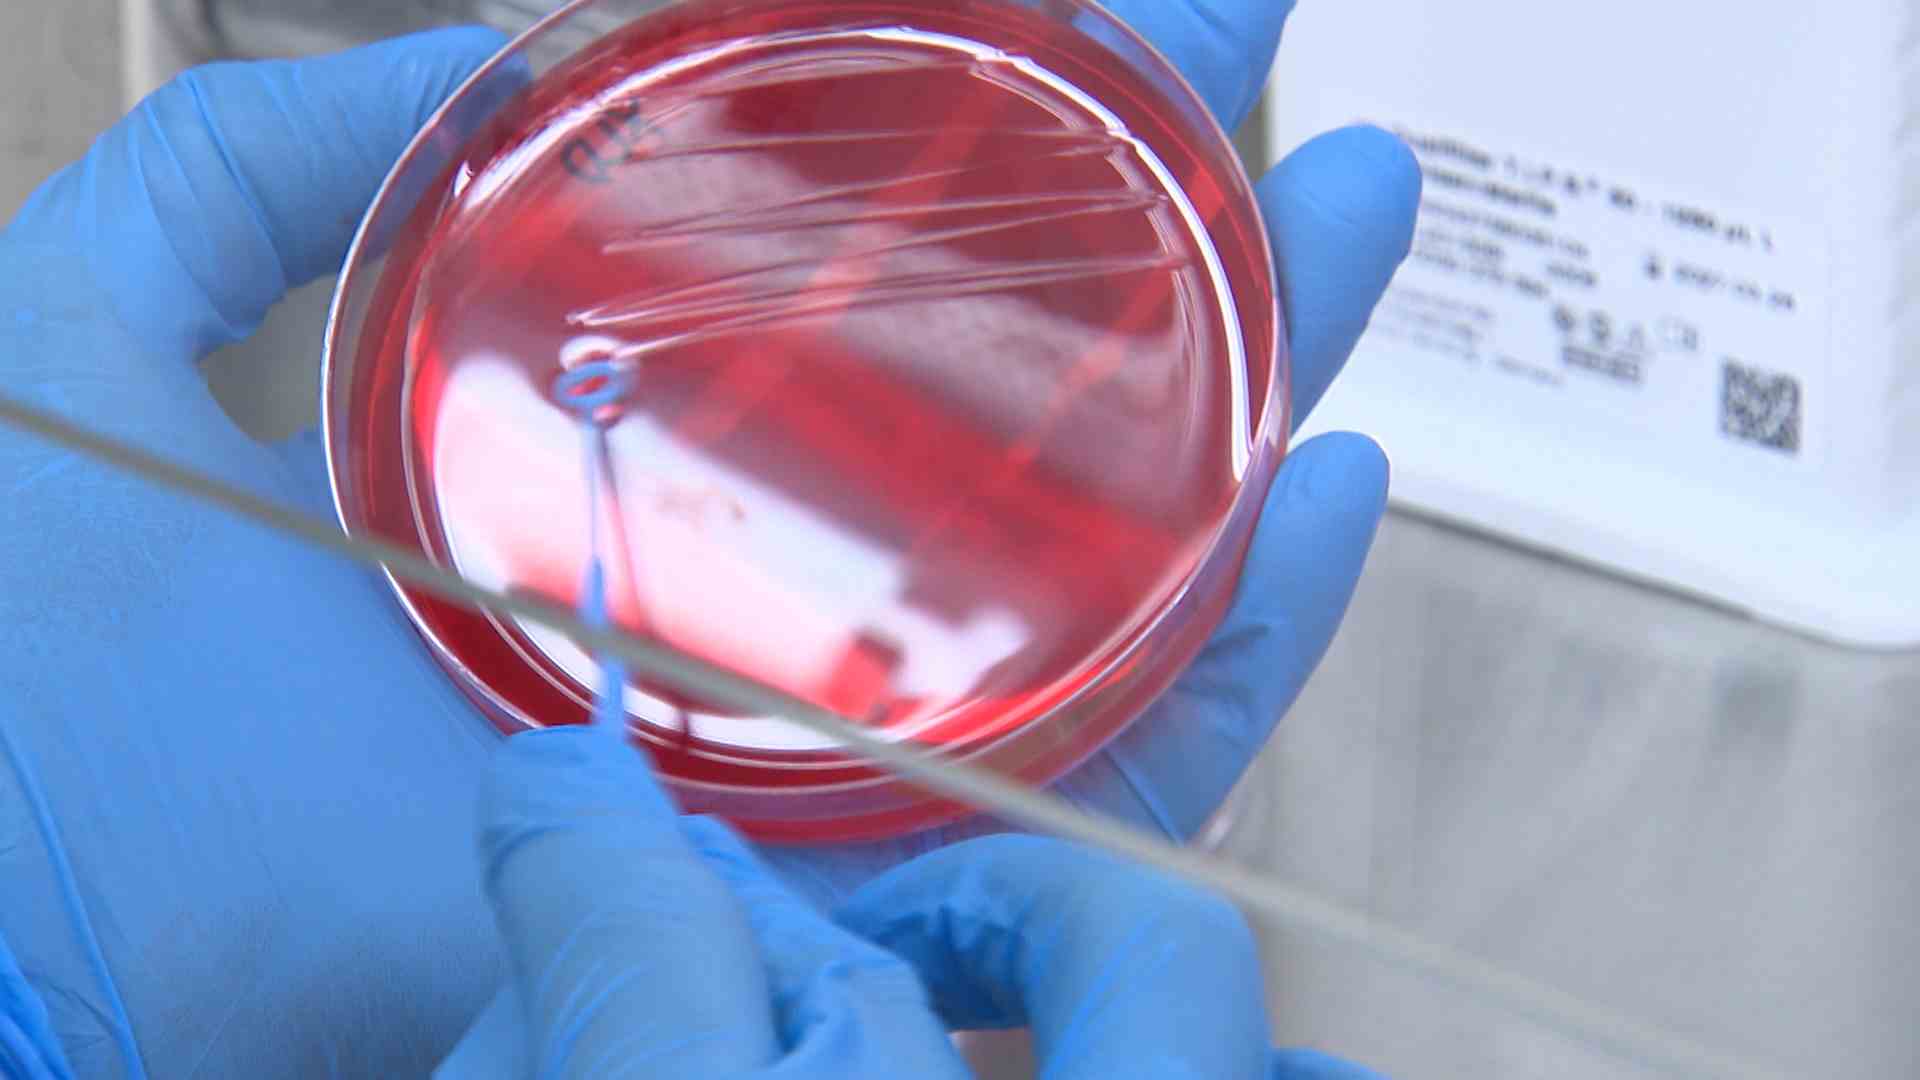

울산시보건환경연구원이 지역사회 감염병 파악과 대응체계 구축을 위해 올해도 하수 기반 감염병 감시 사업을 벌입니다.
감시 대상은 굴화와 용연, 농소, 방어진 하수처리장 4곳의 유입수로 코로나19, 인플루엔자, 급성호흡기 7종, 노로바이러스 등을 검사합니다.
앞서 지난해 하수기 감시에서 코로나19는 하수와 환자 추이가 일치하고, 인플루엔자는 하수가 1주일 먼저 관측되는 등 하수 감시가 인체 감시 결과를 반영하는 것으로 나타났습니다.
Copyright © Ulsan Munhwa Broadcasting Corporation. All rights reserved.

취재기자
enter@usmbc.co.kr